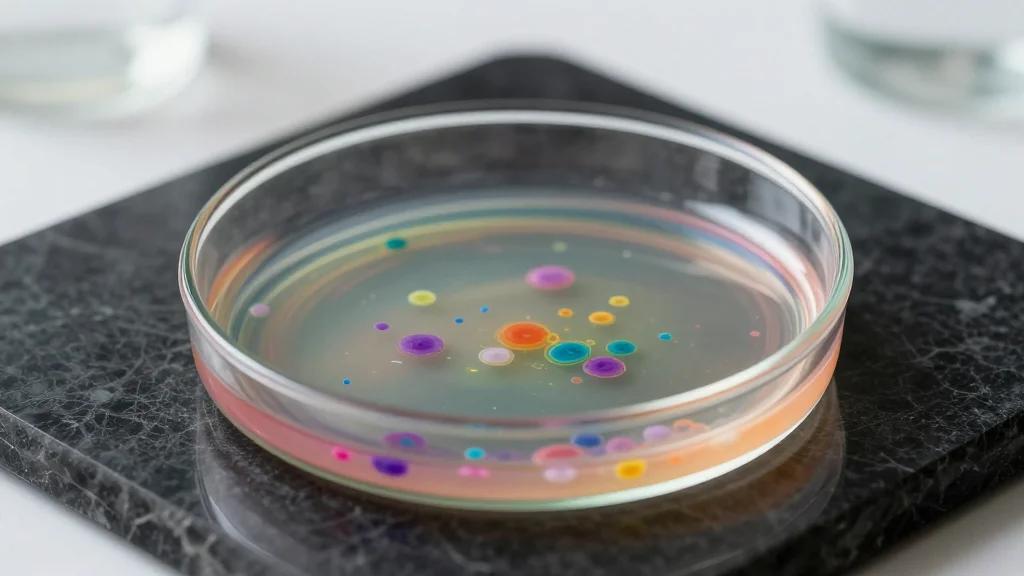
Regulatory Actions for April 16, 2026

Black Forest Power Monsters for the DIN Rail
CAMTEC Power Supplies launched the CPS‑EC2000 series, a 2,000 W DIN‑rail AC/DC power supply built on SiC‑MOSFET technology. The unit delivers laboratory‑grade precision, 94% efficiency, and rapid load response without a programming interface, targeting cost‑sensitive test‑bench and charger applications. Available alongside 480 W, 1,000 W and 1,500 W models, the series meets a broad range of industrial standards. CAMTEC emphasizes robust, all‑metal construction and features such as active inrush limiting and dual 16 mm output terminals.

FDA Webinar on the RCT-DUPLICATE Initiative: Emulating Randomized Clinical Trials with Non-Randomized Real-World Data Studies - 04/29/2026
On April 29, 2026 the FDA hosted a free public webinar to update stakeholders on the RCT‑DUPLICATE demonstration project. The initiative compares non‑randomized real‑world data (RWD) studies with randomized controlled trial (RCT) outcomes to assess causal validity. Findings show strong...

After Opening an Advanced-Tech Hospital, a CIO Discusses Lessons Learned
Children’s Healthcare of Atlanta opened the $2.5 billion Arthur M. Blank Hospital in September 2024, featuring 60+ new systems, 5,500 integrations and the world’s largest autonomous robot fleet. While the infrastructure performed flawlessly, utilization of several technologies lagged, revealing that human workflow friction, not...

Aldi Testing New Store Format in Florida
Aldi began testing a unified global store format at the Promenade Shoppes in Aventura, Florida, in September 2025. The modular design emphasizes operational efficiency, a broader private‑label assortment, and a consistent brand experience across markets. The pilot runs alongside a...

Buy-to-Let Repossessions Rise by 10% as Landlords Face ‘Tough Times’ Ahead – What You Can Do Now
Buy-to-let mortgage repossessions in the UK jumped 10% to 770 properties in Q4 2025, the highest level since 2024. New landlords taking out BTL loans in April face roughly $1,650 higher annual repayments, while rents outside Greater London have flat‑lined...

QVC and HSN Owner Files for Chapter 11 Bankruptcy
QVC Group, the parent of QVC and HSN, announced a Chapter 11 filing and aims to emerge within roughly 90 days. The company says it has ample liquidity to pay all unsecured creditors in full and does not plan any layoffs...

Bullet Points for a Smoother Operation
Small‑market radio stations often falter not because of outdated gear but due to workflow gaps such as undocumented processes and temporary fixes that become permanent. Steve Cannon proposes four operational systems—quarterly automation audits, a single‑path production workflow, monthly engineering walk‑throughs,...

Mercedes C-Class EV Interior Revealed with 39.1in Hyperscreen
Mercedes-Benz unveiled the interior of its upcoming C‑Class EV, featuring a 39.1‑inch MBUX Hyperscreen that stretches across the dashboard. The model shares the 800‑volt MB.EA platform with the electric GLC, delivering a claimed range of more than 450 miles. Luxury...

Now We Know Who Bought London’s Most Expensive Home. He Couldn’t Have Kept It Secret for Long
British tech‑investor Suneil Setiya, founder of Quadrature Capital, purchased London’s Providence House for roughly £270 million (about $340 million), making it the city’s most expensive residential sale. The deal, previously shrouded in secrecy, was confirmed by the Financial Times after Setiya’s £4 million...

FDA Extends Review of Savara’s Molgramostim BLA for PAP
Savara’s inhaled GM‑CSF therapy, molgramostim, received a three‑month FDA review extension, moving the PDUFA target action date to November 22, 2026. The extension follows the agency’s classification of the company’s recent data submissions as a major amendment, but it did not signal...

Montreal School Board Loses 150 Workers Under Secularism Law
Montreal’s largest school service centre, the Centre de services scolaire de Montréal, has terminated roughly 150 support staff who refused to remove religious symbols under Quebec’s new Bill 94. The law, adopted in October 2025, widens the province’s secularism ban from teachers...

Scottish Retail Body Criticises SNP Proposal for Food-Price Caps
The Scottish Retail Consortium (SRC) has slammed the Scottish National Party’s (SNP) election‑time proposal to impose statutory price caps on 20‑50 essential food items at large supermarkets, calling it a gimmick. The SNP, led by John Swinney, argues caps will shield...

Renfe Withdrawal From France Puts Talgo’s €350m Le Train Deal at Risk
Talgo’s €350 million (about $381 million) contract to supply up to ten Avril high‑speed trains to French private operator Le Train is now in jeopardy after Renfe scrapped its planned expansion into France. The deal depended on the Avril units being homologated on...

Amtrak Issues RFP for Long-Distance Fleet
Amtrak has released an RFP for over 800 single‑deck long‑distance coaches to replace aging equipment on 14 routes. The new fleet will standardize cars, improve amenities, and is slated for award by the end of 2027. The move follows a...

Targeting an Appetite Hormone Receptor for Stronger Muscles
Researchers published in Aging Cell that suppressing the ghrelin receptor (GHSR‑1a) improves muscle performance and mitigates sarcopenia in aged mice. Genetic knockout of GHSR‑1a extended running endurance by up to 45% and reduced muscle fatigue, while preserving mitochondrial function through...

UPDATED | Senate Overturns Protections For Boundary Waters Canoe Area Wilderness
The U.S. Senate approved HJ Resolution 140 by a 50‑49 vote, overturning a two‑decade mineral withdrawal that shielded the Boundary Waters Canoe Area Wilderness in Minnesota. The repeal removes protection for roughly 225,000 acres, paving the way for a Chilean...

Pano Investigation: No Evidence of Russian Drones in Belgium Despite €50m Emergency Spend
The Belgian TV program Pano found no verifiable evidence of Russian drones over Belgium, contradicting Defence Minister Theo Francken’s public warnings. An emergency procurement of counter‑drone systems cost about €50 million ($55 m) and was executed without a standard tender, leading to...

Canada’s Antimony Gap Shows as Iran War Sharpens Focus on Defence Metals
The war in Iran has thrust antimony into the spotlight as a defence‑critical metal, with 40% of U.S. use last year going into ammunition and flares. Canada classifies antimony as critical but lacks a dedicated policy, leaving a thin project...

Experimental Operations Unit Accelerates Collaborative Combat Aircraft Program
The Air Force’s Experimental Operations Unit (EOP) wrapped up a pivotal exercise with the Collaborative Combat Aircraft (CCA) at Edwards Air Force Base. The drill united test authorities from Air Force Materiel Command with operational leaders from Air Combat Command,...

Massachusetts Senate Passes Bill Addressing Bags, Foam, Foodservice Packaging
The Massachusetts Senate approved S.3050, a $3.6 billion environmental bond, by a 36‑3 vote, sending it to the House. The legislation adds paint extended producer responsibility, bans single‑use plastic carry‑out bags and requires retailers to charge at least a 10‑cent fee...

India and Pakistan Still Cannot Agree to Restore the Indus Waters Treaty – but Re-Engagement Could Help Bring Lasting...
India has suspended its participation in the 1960 Indus Waters Treaty following the 2025 Pahalgam attack, cutting water flows through the Baglihar and Kishanganga dams. The treaty, which has underpinned water sharing for over 300 million people, is now under strain...

This Week’s MPN Video Podcast: Why Live Sports Streaming Still Breaks — And How to Fix It
The Media Play News podcast hosted by David Bloom and Daniel Frankel featured NetSkrt CEO Sig Luft discussing why live‑sports streaming continues to falter. Luft highlighted persistent CDN bottlenecks, edge‑delivery constraints, and latency issues that jeopardize viewer experience and real‑time...

Cuba: The Bay of Pigs Invasion 65 Years Later
On the 65th anniversary of the Bay of Pigs, the National Security Archive released a trove of declassified documents revealing President Kennedy’s contemplation of CIA restructuring after the fiasco. A secret memo shows White House aide Arthur Schlesinger studying the...

USCM, Columbia University Eye Defence-Critical Metals in Red Mud
US Critical Materials Corp. and Columbia University have signed a two‑year research pact to extract defence‑critical metals from red mud, the waste by‑product of aluminium refining. The "Mud to Metal" program will focus on gallium, scandium, titanium and rare‑earth elements,...

How Gen Alpha Is Changing the In-Store Experience
A recent MG2 Advisory survey shows 73% of Gen Alpha favor brick‑and‑mortar shopping over e‑commerce, sparking a resurgence in mall traffic. Retailers are responding by turning stores into experiential "third spaces" with coffee shops, DJ sets, pop‑up events and creator‑driven...

Point Reyes Pays Close Attention to How People Use Flavored Cheeses
Point Reyes is intensifying its focus on how consumers incorporate flavored cheeses into everyday meals. The brand recently introduced three herb‑infused varieties and revamped packaging to resealable pouches after extensive in‑store usage testing. Data show that 68% of shoppers pair...

Steel Producers Tease Q1 Earnings Surge, Citing Higher Prices
U.S. steelmakers Nucor and Steel Dynamics are projecting a sharp rise in first‑quarter earnings, buoyed by higher sales volumes and prices after Section 232 tariffs redirected demand to domestic producers. Both firms expect earnings per share to climb roughly $1 versus...

L3Harris Technologies Plans $1.3B Solid Rocket Motor Expansion in Virginia
L3Harris Technologies announced a $1.3 billion expansion of its solid‑rocket‑motor (SRM) manufacturing campus in Orange County, Virginia, which will more than double production space and create over 350 jobs. The effort builds on a $41.2 million upgrade launched earlier this year and...

Conecta Magaluf–Mallorca Announces First Speakers and Unveils New Meeting Model
Conecta Magaluf–Mallorca announced its first international speakers and introduced a new "Focus On" format that replaces traditional Country Spotlights with curated 1‑to‑1 meetings for audiovisual decision‑makers. The lineup features executives from major European broadcasters, production houses, and a U.S. producer...

Transparent Window Insulation Is Better at Stemming Energy Loss, Manufacturer Says
Global Holdings is retrofitting over 2,000 windows at New York’s 39‑story Nomad Tower with LuxWall’s transparent window insulation. The technology promises a 20% reduction in building energy use and an R‑value of 18—about 18 times the performance of existing glazing....

Kentucky Is Getting Its First Pumped Storage Hydropower Project for $1.3B
Kentucky is set to launch its first pumped‑storage hydropower facility, a $1.3 billion venture aimed at bolstering grid reliability. The project will deliver roughly 1 GW of reversible generation, enabling large‑scale energy storage for renewable integration. Backed by a public‑private partnership, the...

Anthropic Unveils Large London Office Expansion
Anthropic announced a major London expansion, adding office space for roughly 800 employees and bringing its UK headcount to about 1,000. The new premises will sit in the city’s Knowledge Quarter, joining other AI giants competing for talent and infrastructure....

Rio Tinto Commissions New Alumina Conveyor at British Columbia Smelter
Rio Tinto has commissioned a new 1.1‑kilometre alumina conveyor at its BC Works smelter in Kitimat, British Columbia, as part of a C$135 million (≈ US$100 million) upgrade. The system will transport up to 800,000 tonnes of alumina per year and is built to...

Poland’s Atlas Arena Completes Renovation
Poland’s Atlas Arena in Łódź has finished a major renovation, boosting its live‑music capacity from 13,800 to 14,728 seats. The upgrade introduces a modular curtain system and mobile stands, giving promoters greater staging flexibility and improving attendee safety. Management says...

A Knight of the Seven Kingdoms Is Forced to Pause Filming as Severe Flooding Leaves Set Underwater
HBO’s A Knight of the Seven Kingdoms halted production after Storm Therese flooded its Gran Canaria set, submerging medieval structures near the Presa de Las Niñas reservoir. The island’s worst storm in a decade forced a state of emergency and will require environmental cleanup before filming can...

Africa Has Turned the Screw on Its Gold Miners. Just Ask Gold Fields
Ghana has introduced a sliding‑scale royalty that will take gold earnings from 5% up to 12% as prices rise, and it is renegotiating mining licences on a case‑by‑case basis. Gold Fields, which relies on the Tarkwa mine for about 17%...

Musterdepot – Zukunft: In Unsicheren Zeiten Auf Die Moderne Infektionsmedizin Setzen
Investors are shifting focus from over‑valued tech names to the neglected anti‑infective sector as 2026 sees a market rotation. High‑priced AI and cloud stocks can tumble on modest earnings misses, prompting fund managers to seek defensive biotech exposure. Modern infection...

Mortgage Rates Drop to 6.3%
The Freddie Mac 30‑year mortgage rate slipped 7 basis points to 6.30% after a cease‑fire was announced in the Iran conflict, a move mirrored by a decline in the 10‑year Treasury yield. While the dip offers a brief reprieve, its durability...

5W PR Launches Digital Growth Program Tailored to B2B Clients
5W PR unveiled a new digital growth program aimed at B2B companies in technology, enterprise solutions, and professional services. The offering fuses public relations, search‑engine optimization, generative engine optimization (GEO) and content creation into a single growth engine. It promises...

EU Age Verification App Announced To Protect Children Online
The European Commission announced that a new age‑verification app is technically ready for rollout, allowing users to prove they are over a required age without disclosing personal identity. The app will be downloaded from standard app stores and set up...

Roblox’s AI Assistant Gets New Agentic Tools to Plan, Build, and Test Games
Roblox announced a suite of agentic features that upgrade its Roblox Assistant from a simple prompt‑response tool to a collaborative development partner. The new Planning Mode lets the assistant analyze code, ask clarifying questions, and generate editable action plans before...

Save over 40% Off Fire TV Devices in April
Amazon is offering deep April discounts on its entire Fire TV lineup, with savings of up to 43% off regular prices. The Fire TV Stick HD is now $20 (down from $35), the 4K Select model $25 (from $40), and...

Jollibee’s Compose Coffee Off to Hot Start in Taiwan
Jollibee Foods Corp.’s South Korean coffee brand Compose Coffee reported a strong pre‑opening turnout at its first Taiwan store, indicating robust consumer demand. The brand, which now operates about 3,000 outlets worldwide, plans to leverage its simple, value‑focused store model...

Marcos Issues Negative List for Foreign Investments
President Ferdinand "Bongbong" Marcos issued Executive Order 113, unveiling the Philippines' 13th regular foreign‑investment negative list. The order replaces the 2022 list and delineates activities fully closed to foreign capital (List A) and those with capped foreign equity (List B). Key sectors...

New Idaho Laws Promote 'Starter Homes' With Lots as Small as 1,400 Square Feet
Idaho lawmakers approved two bills aimed at expanding affordable starter‑home options. SB 1352 allows municipalities to approve residential lots as small as 1,400 square feet, the smallest minimum lot size in the United States, and eases traditional setbacks. SB 1354 bars local...

Election Ad Spending Drives up GMA Profit in 2025
GMA Network Inc. posted a 6% rise in net income to PHP2.2 billion (≈$40 million) in 2025, driven by a 3% jump in revenue to PHP18.12 billion (≈$326 million). Political advertising during the mid‑term elections lifted advertising sales to PHP16.57 billion, representing over 90% of...

Integrated Care Needed as Metabolic Disease Prevalence, Costs Climb, Experts Say
At the AMCP 2026 meeting, experts warned that metabolic disease now affects over 40% of U.S. adults and is driving rising health‑care costs. Claims data from a 22‑million‑member commercial population show metabolic conditions accounted for 13% of total spending in 2024,...
Regulatory Actions for April 16, 2026
BioWorld’s April 16, 2026 regulatory snapshot lists a flurry of biopharma and med‑tech actions, ranging from new drug submissions to market approvals and designations. Companies such as Airs, Aligos, AOP, Arbutus, Cala, Dogwood, Immutep, Leadiant, Northstar, Opna, Reach Surgical, Waters and Xspray...

Can the Arctic Council Survive?
The Arctic Council is grappling with a leadership vacuum after Greenland’s foreign minister resigned, leaving the rotating chairmanship unfilled. Simultaneously, renewed U.S. interest in Greenland and lingering Russia‑Ukraine tensions have heightened geopolitical pressure on the intergovernmental forum. Despite these strains,...

Despite the Government’s Ban, Netgear Just Got an Exemption to Keep Selling New WiFi Routers in the U.S.
The Federal Communications Commission granted Netgear an exemption that lets the company sell new foreign‑made Wi‑Fi routers in the United States through October 1, 2027, despite a recent ban on all new overseas router models. The exemption still requires each new Netgear...